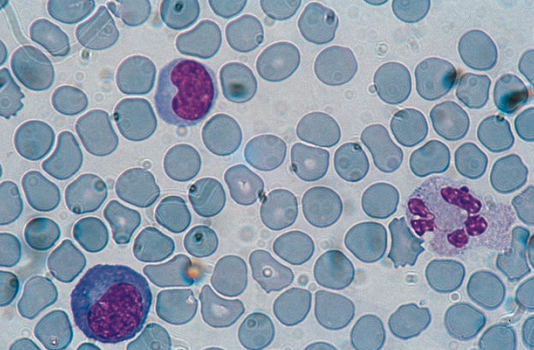

1
/
of
2
May Grunwald Giemsa for Smears
May Grunwald Giemsa for Smears
Regular price
Dhs. 0.00 AED
Regular price
Sale price
Dhs. 0.00 AED
Unit price
/
per
Download Product's Datasheet
Product for the preparation of cyto-histological samples for optical microscopy. Recommended method to differentiate cell types and to reveal parasites in blood smears, morphologic details in spleen tissue, lymph node tissue and marrow, to demonstrate bacteria, rickettsia and mast cells granulation in sputum and organic aspirates. Particularly recommended to detect Trichomonas in vaginal smears.
- May Grunwald solution, consisting of eosin-methylene blue, stains nuclei blue and basophil cytoplasm pinkish red.
- Giemsa solution, a complex consisting of methylene blue chloride, eosin-methylene blue and azure II eosinate, improves the intensity of nuclear staining and the capacity to show selectively cellular structures. To appreciate results always remember two factors: pH of washing water and dilution buffer have a strong influence on final colour chart; intensity of stain may vary according to differentiation time.
METHOD:
1) In a volumetric flask 1000 ml, put 100 ml of reagent B (buffer - concentrated solution) and reach the volume with running tap water (buffer - working solution). Keep buffer solutions at 4-6 °C.
2) Put 10 drops of reagent A on the slide: leave to act 5 minutes. N.B. Step 2 may be done in a Coplin Jar without modifying working times. In this case, reagent should be kept for further use.
3) Wash in running tap water for 1 minute.
4) Add 10 ml of reagent C in a cylinder with 90 ml of buffer solution B (working solution), pour the obtained solution in a Coplin jar and immerse the slide for 15 minutes.
5) Wash in running tap water for 1 or 2 minutes.
6) Dry the slide with filter paper then in the air for 5 minutes.
Share
No reviews